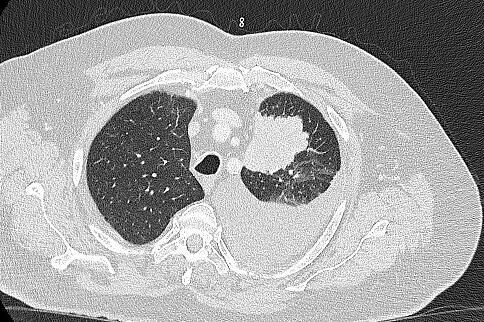

Zum Weltkrebstag am 4. Februar: Hilfe bei Lungenkrebs finden
Zirka 85.000 Krebserkrankungen jährlich sind in Deutschland allein dem Rauchen zuzuschreiben. Rauchen ist mittlerweile der wichtigste Krebsrisikofaktor für Männer.

Das Krebsregister Berlin-Brandenburg weist für Brandenburg im Jahr 2022 17.463 Menschen mit Krebserkrankungen aus. Zuletzt sind in einem Jahr 8.400 Menschen an der Krankheit gestorben. Krebserkrankungen sind mit einem Anteil von 23 Prozent nach Erkrankungen des Herz-Kreislauf-Systems die zweithäufigste Todesursache. Die häufigsten Krebsarten bei Männern in Brandenburg sind Lungen- und Prostatakrebs, Frauen erkranken am häufigsten an Brust- oder Darmkrebs.
Hilfe finden bei Lungenkrebs
Ein Leuchtturm für die Lungenkrebsbehandlung im Land Brandenburg ist die Johanniter-Lungenfachklinik in Treuenbrietzen
Das hier seit 21 Jahren bestehende Thoraxzentrum ist seit kurzem als Exzellenzzentrum der Deutschen Gesellschaft für Thoraxchirurgie zertifiziert
Das ist das höchste erreichbare Level der fachlichen Auszeichnung in Deutschland - ein echtes Qualtätszertifikat. Bereits seit 2011 ist die Klinik zudem als Kompetenzzentrum Thoraxchirurgie und als Lungenkrebszentrum der Deutschen Krebsgesellschaft zertifiziert.
Der Chefarzt Thoraxchirurgie, Dr. Olaf Schega, sagt: „Wir als chirurgisches Exzellenzzentrum leisten hochqualitative Operationen, nach denen Patienten mit Lungenkrebs wieder eine Perspektive haben können, wenn die Erkrankung rechtzeitig im Frühstadium erkannt wird. Wer wie wir im Jahr knapp 1.000 Operationen durchführt, kann einen riesigen Erfahrungsschatz vorweisen."
Der Ärztliche Direktor Dr. Karsten Haitsch ergänzt: „Seit vielen Jahren arbeitet das thoraxchirurgische Team um Dr. Olaf Schega – Ärzte, OP-Pflegekräfte, Anästhesie - in nahezu unveränderter Besetzung bereits miteinander – ein Erfahrungsschatz, der seinesgleichen sucht! Das Exzellenzzentrum mit seinen hohen Leistungszahlen gilt auch bei unseren Zuweisern als sehr profiliert in der Behandlung von Lungenkrebs …“
Zudem haben die Johanniter in Treuenbrietzen mit einer onkologischen Tagesklinik und einer spezialisierten pneumologischen MVZ-Praxis ergänzende Behandlungsmöglichkeiten für Lungenkrebspatienten.